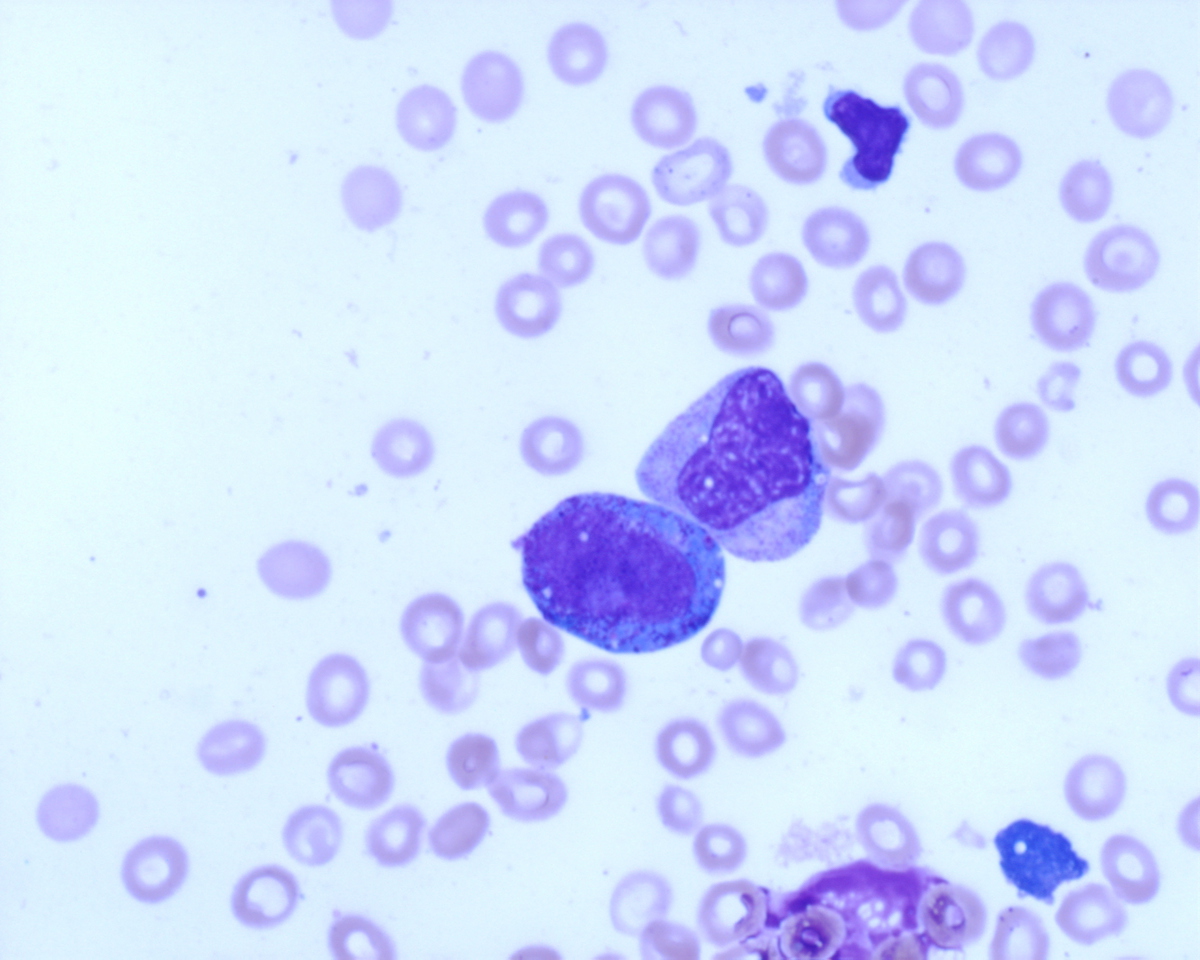
direct smear 60X blast
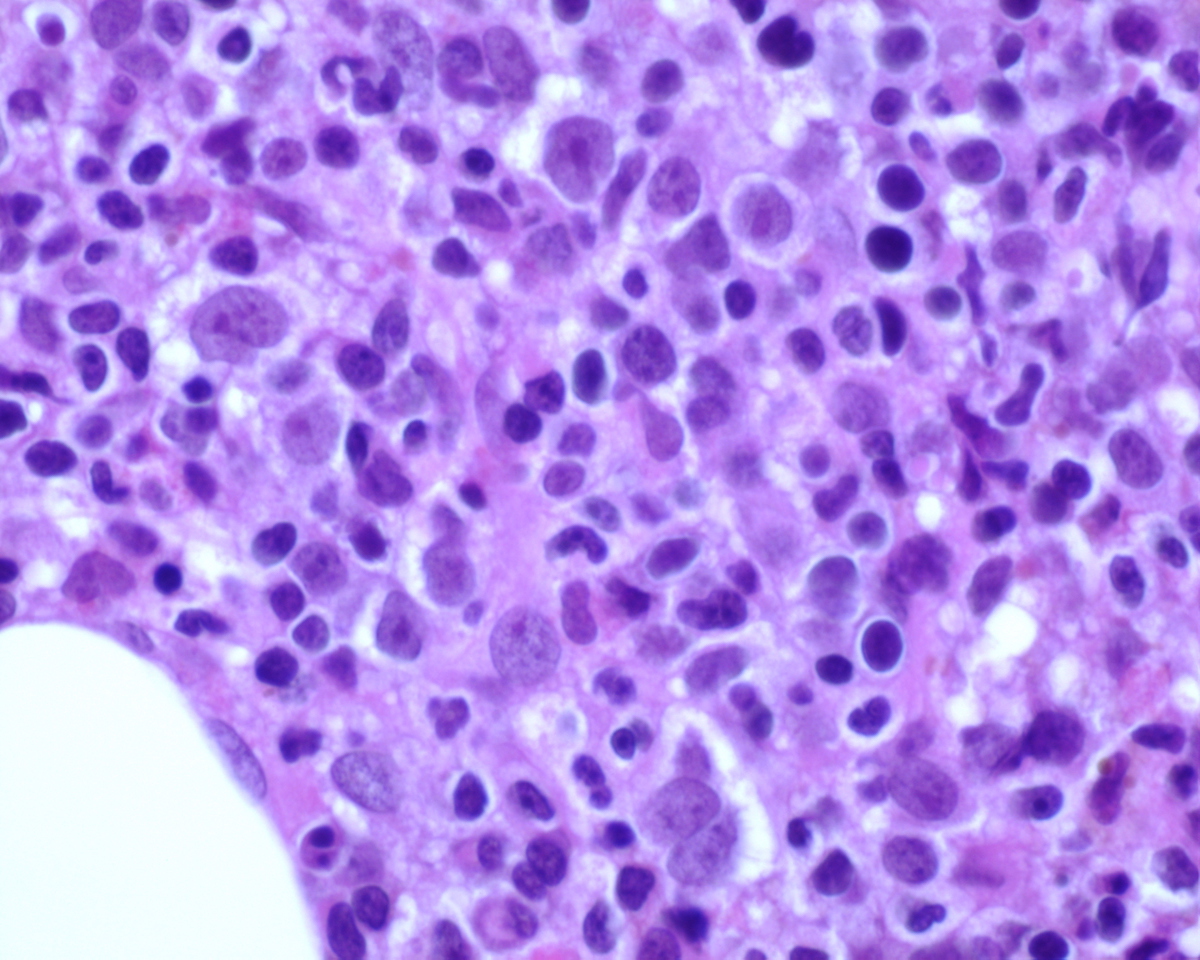
Core BX high power 60X
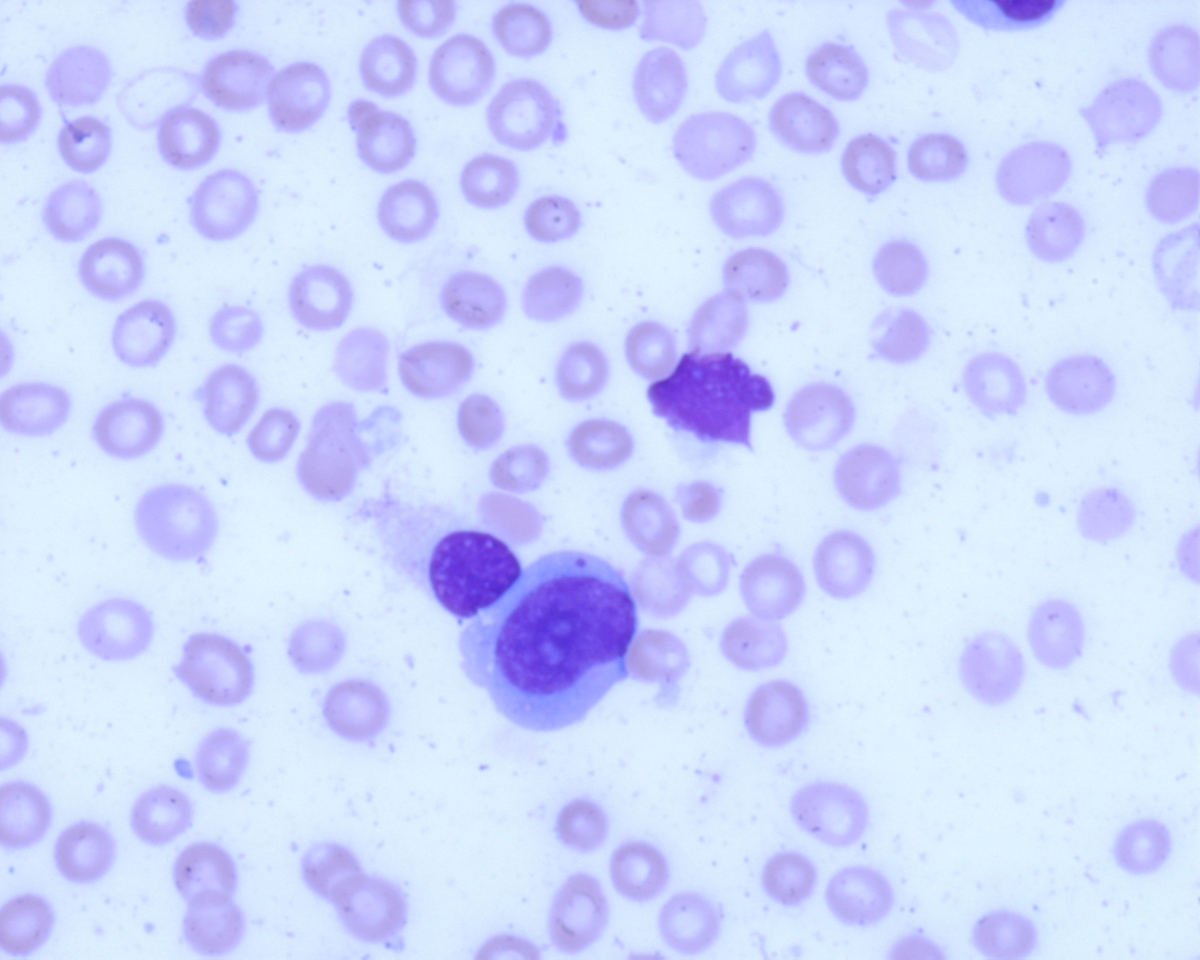
direct smear 60X blast

Institution: Department of Pathology and Laboratory Medicine, Hematopathology Division, UMDNJ - Robert Wood Johnson Medical School
Additional authors:Gratian Salaru MD, Sharathkumar Baghavathi MD, David Weismann MD, Lauri Goodell MD
Session: AML secondary to myeloproliferative neoplasms and other types of disease progression in MPN
HISTORY
80 year old male with peripheral peripheral blood leukocytosis at the beginning of 2005. Bone marrow biopsies performed at the beginning and the end of 2005 revealed hypercellular for age bone marrow with hyperplastic maturing hematopoiesis, with notable erythroid and megakaryocytic hyperplasia. The latter exhibited mild left shift and smaller forms with occasional clustering on biopsy sections. BCR/ABL was negative by FISH and PCR. Chromosomal analysis showed normal male karyotype. Both specimens were signed out as myeloproliferative neoplasm, with an accompanying note listing Polycythemia Vera and Essential Thrombocythemia as differential diagnoses. The patient presents in early 2013 with pancytopenia and peripheral blasts.
DETAILS
Bone marrow aspirate direct and particle smears, blood clot, right iliac crest biopsy and accompanying peripheral blood smear were received. The peripheral blood, direct and particle smears were stained with Wright-Giemsa stain. The clot and core biopsy were fixed in 10% buffered formalin and the biopsy was decalcified in formic acid bone decalcifier (Immunocal). The peripheral blood smear shows pancytopenia with anisocytosis, and a leukoerythrobastic reaction. No Auer rods are noted on the circulating blasts. Occasional neutrophils appear dysplastic with hypogranulation and hyposegmentation. The bone marrow smears were hemodilute and showed no significant dyspoiesis in the erythroid and granulocytic series. Megakaryocytes were predominantly small sized and left shifted. The decalcified bone marrow biopsy is hypercellular for age with markedly increased immature precursors with prominent nucleoli. The few fully mature megakaryocytes present do not show morphologic features associated with ET. Increased numbers of micromegakaryocytes as well as small, left shifted megakaryocytes are present.
IMMUNOHISTOCHEMISTRY AND FLOW CYTOMETRY
Immunohistochemical stains showed marked increase of megakaryocytes, including numerous small, monolobated forms, which are strongly positive for CD61. CD34 and CD117 highlight increased immature cells, approximately 10% of the nucleated marrow elements. Reticulin shows mild diffuse increase in fiber deposition. An iron stain shows adequate stainable iron. Immunophenotyping by flow cytometry reveals approximately 7% of the total gated events in the dim CD45 positive gate, which coexpress CD34, CD117 and myeloid antigens. A subset of the cells coexpress CD41 and CD61 indicating megakaryocytic lineage.
CYTOGENETIC FINDINGS
Complex karyotype
44-46,XY,add(3)(p13),-17,add(17)(p11.2),-18,-20,+dup(21)(q11.2;q22)x3[cp21]
Abnormal male karyotype with structural abnormaliy of chromosomes 3p, 17p, loss of chromosomes 17, 18 and 20 and additional three copies of a duplicated chromosome 21 in all cells.
nuc ish (RUNX1T1X2,RUNX1X4~8)[128/200]
Abnormal result with gain of 4 to 8 copies of probe RUNX1 on chromosome 21 and normal result with probe RUNX1T1 on chromosome 8 in 128 of 200 cells.
nuc ish (ABL1,BCR)x2[200]
nuc ish (MLLx2)[200]
nuc ish (D5S23,EGR1)x2[200]
nuc ish (D7Z1,D7S486)x2[200]
nuc ish (D8Z2,D20S108)x2[200]
Normal result with probes ABL1 and BCR for translocation (9;22) in 200 interphase cells.
Normal result with probe MLL on chromosome 11q23 in 200 interphase cells.
Normal result with probes D5S23 and EGR1on chromosome 5 in 200 interphase cells.
Normal result with probes D7Z1 and D7S486on chromosome 7 in 200 interphase cells.
Trisomy 8 and deletion of the long arm of chromosome 20 were not detected with probes D8Z2 and D20S108 in 200 interphase cells.
PCR for JAK2 mutation is pending.
MOLECULAR FINDINGS
INTERESTING FEATURES
Complex karyotype with multiple structural abnormalities, and amplification of RUNX1 on chromosome 21.
PROPOSED DIAGNOSIS
HYPERCELLULAR BONE MARROW WITH INCREASED MYELOID BLASTS AND IMMATURE MEGAKARYOCYTES, HIGHLY SUSPICIOUS OF EVOLVING MEGAKARYOBLASTIC LEUKEMIA.
CONSENSUS DIAGNOSIS
Myeloproliferative neoplasm, NOS, in accelerated phase
| direct smear 60X blast | |
| direct smear 60X micromegakaryocyte |  |
| Core BX low power |  |
| Core BX high power 40X |  |
| Core BX high power 60X | |
| Immunohistochemistry CD61 |  |
| Immunohistochemistry CD34 |  |
| Immunohistochemistry CD117 |  |
| direct smear 60X blast | |